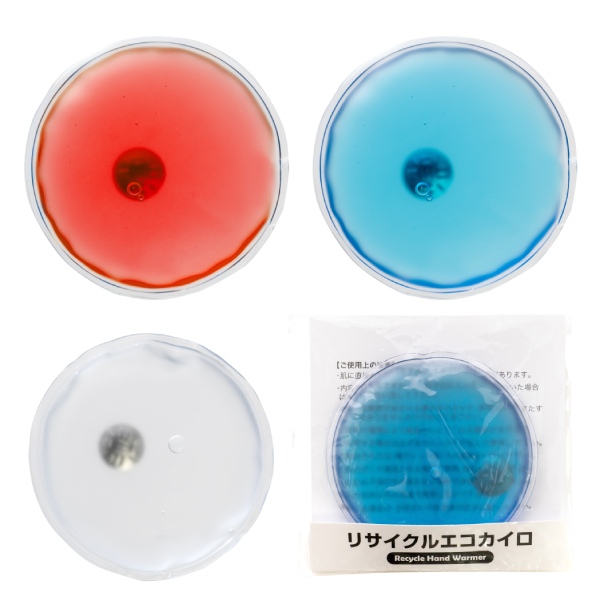
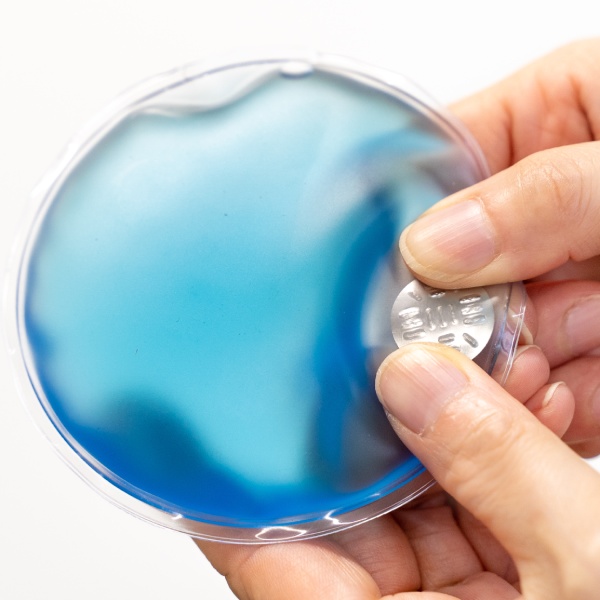
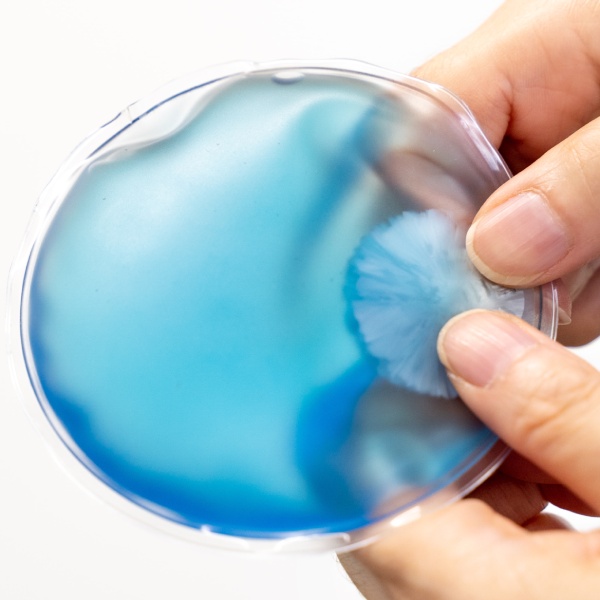
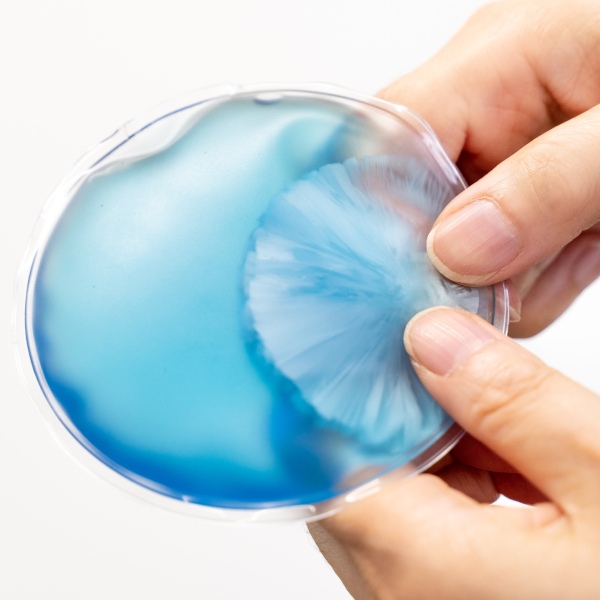

- 周年記念品・創立記念品(2768)
- 卒業記念品・卒園記念品(2236)
- スプリング・サマーグッズ(1574)
- 粗品・景品・販促品(1989)
- ウィンターグッズ(453)
- 年始グッズ・干支グッズ(539)
- 子供向けノベルティ(679)
- 男性向けノベルティ(283)
- 女性向けノベルティ(718)
- レザー・合皮(117)
- ガラス・クリスタル(298)
- ウッド(木製)(484)
筆記用具
- ボールペン(137)
- ボールペン(国内ブランド)(357)
- ボールペン(海外ブランド)(205)
- 多色ボールペン(27)
- 多色ボールペン(国内ブランド)(83)
- 複合筆記具・多機能ボールペン(48)
- 複合筆記具(国内ブランド)(133)
- シャープペン(14)
- シャープペン(国内ブランド)(194)
- シャープペン(海外ブランド)(24)
- 万年筆(141)
- 万年筆(海外ブランド)(79)
- 蛍光ペン・マーカー・サインペン(275)
- ペンセット(蛍光ペン・マーカー・サインペン)(184)
- 筆ペン(37)
- 鉛筆・色鉛筆(203)
- クレヨン・絵の具(85)
- 筆記具セット(81)
- その他筆記具(102)
ステーショナリー
- 2026年版名入れ卓上カレンダー(227)
- 2026年版名入れ壁掛けカレンダー(288)
- 2026年版ダイアリー・手帳(151)
- タブレット・パソコングッズ(87)
- USBメモリー(18)
- モバイルバッテリー・モバイルチャージャー(132)
- モバイル・スマホグッズ(179)
- タッチペン・スタイラスペン(37)
- モバイル・スマホスタンド(66)
- 印鑑・印鑑ケース・スタンプ台(189)
- マグネット(188)
- クリップ・スタンド(115)
- 電卓・電子辞書(9)
- 付箋(フセン)(217)
- メモ帳・メモケース(108)
- ノート(544)
- 手帳・システム手帳(24)
- ブックカバー・しおり(17)
- ペンケース(113)
- クリアファイル・書類ホルダー(470)
- バインダー・リングファイル・フラットファイル(232)
- 文具セット(26)
- ルーペ・ペーパーウェイト(140)
- 万年カレンダー・カレンダー類(17)
- ビジネスアイテム(89)
- 定規(112)
- 修正テープ・修正ペン(74)
- 消しゴム(111)
- のり・テープ・テープカッター(84)
- その他文具ノベルティ(456)
美容・健康
- マスク・マスクケース(120)
- 美容関連ノベルティ(126)
- コスメポーチ(120)
- あぶらとり紙(44)
- ミラー(117)
- 爪切り・ネイルケア(47)
- バスグッズ(128)
- 入浴剤(198)
- リラックス・癒しグッズ(127)
- ピルケース・サプリメントケース(18)
- 保険証ケース(11)
- 体脂肪計・歩数計(21)
- 健康・医療(457)
アウトドア・ホビー
- アウトドア・レジャー(377)
- クーラーバッグ(85)
- ランチボックス(96)
- ボトル・ボトルケース(284)
- ボトル・ボトルケース(国内ブランド)(72)
- エコカイロ・カイロケース・湯たんぽ(71)
- トラベルグッズ(101)
- スポーツ(128)
- カーグッズ(46)
- ガーデニング(29)
- 傘・雨具(163)
- 催事用品(105)
フード・家庭用品
- マグカップ(304)
- タンブラー・マグボトル(414)
- タンブラー・マグボトル(国内ブランド)(163)
- 箸・箸袋・箸置き(507)
- カトラリー(179)
- テーブルウェア・食器(367)
- グラスタンブラー・グラスマグ(44)
- コースター・ストロー(47)
- キッチン(1136)
- キッチンタイマー(19)
- 食品・調味料(576)
- 飲料(169)
- お菓子(308)
- お菓子【名入れ専用】(44)
- タオル・手ぬぐい(514)
- 名入れタオル・名入れハンカチ(194)
- ハンディファン・携帯扇風機(46)
- 消耗品(595)
- ティッシュ・ウェットティッシュ(337)
- クリーングッズ(509)
- ソーイングセット(13)
- シューズ関連(110)
- メジャー(18)
- 工具・DIYツール(23)
- 防災アイテム(561)
- 防災セット(235)
- 防犯・セキュリティグッズ(65)
- 防犯ブザー・ホイッスル(45)
- その他生活関連ノベルティ(640)
- カタログギフト(119)
バッグ・ファッション
- エコバッグ・トートバッグ(394)
- エコバッグ・トートバッグ(折畳み)(206)
- コットンバッグ(288)
- 厚手コットンバッグ(210)
- 保温・保冷バッグ(156)
- 紙袋・ギフトバッグ(58)
- ポーチ・巾着(542)
- バッグ(214)
- リュック・ナップサック(35)
- 扇子(760)
- うちわ(398)
- 名入れTシャツ・ウエア・帽子(820)
- エチケットブラシ・洋服ブラシ(25)
- ハンカチ・ハンドタオル(295)
- カードケース・パスケース・名刺入れ(103)
- キーホルダー・ストラップ(131)
- ブランケット・ひざ掛け(75)
- ライター・灰皿(2)
- その他ファッションノベルティ(254)
時計・インテリア他
- 時計(デジタル)(73)
- 時計(アナログ)(172)
- 電波時計(デジタル)(65)
- 電波時計(アナログ)(46)
- 温湿度計(99)
- フォトフレーム(358)
- フォトアルバム(144)
- ライト・LEDライト(248)
- ラジオ(22)
- ラック・トレー・スタンド(93)
- パズル・おもちゃ(271)
- トロフィー・楯・オーナメント(110)
- その他インテリア・雑貨(315)
- 周年記念品・創立記念品(2768)
- 卒業記念品・卒園記念品(2236)
- スプリング・サマーグッズ(1574)
- 粗品・景品・販促品(1989)
- ウィンターグッズ(453)
- 年始グッズ・干支グッズ(539)
- 子供向けノベルティ(679)
- 男性向けノベルティ(283)
- 女性向けノベルティ(718)
- レザー・合皮(117)
- ガラス・クリスタル(298)
- ウッド(木製)(484)
- ボールペン(137)
- ボールペン(国内ブランド)(357)
- ボールペン(海外ブランド)(205)
- 多色ボールペン(27)
- 多色ボールペン(国内ブランド)(83)
- 複合筆記具・多機能ボールペン(48)
- 複合筆記具(国内ブランド)(133)
- シャープペン(14)
- シャープペン(国内ブランド)(194)
- シャープペン(海外ブランド)(24)
- 万年筆(141)
- 万年筆(海外ブランド)(79)
- 蛍光ペン・マーカー・サインペン(275)
- ペンセット(蛍光ペン・マーカー・サインペン)(184)
- 筆ペン(37)
- 鉛筆・色鉛筆(203)
- クレヨン・絵の具(85)
- 筆記具セット(81)
- その他筆記具(102)
- 2026年版名入れ卓上カレンダー(227)
- 2026年版名入れ壁掛けカレンダー(288)
- 2026年版ダイアリー・手帳(151)
- タブレット・パソコングッズ(87)
- USBメモリー(18)
- モバイルバッテリー・モバイルチャージャー(132)
- モバイル・スマホグッズ(179)
- タッチペン・スタイラスペン(37)
- モバイル・スマホスタンド(66)
- 印鑑・印鑑ケース・スタンプ台(189)
- マグネット(188)
- クリップ・スタンド(115)
- 電卓・電子辞書(9)
- 付箋(フセン)(217)
- メモ帳・メモケース(108)
- ノート(544)
- 手帳・システム手帳(24)
- ブックカバー・しおり(17)
- ペンケース(113)
- クリアファイル・書類ホルダー(470)
- バインダー・リングファイル・フラットファイル(232)
- 文具セット(26)
- ルーペ・ペーパーウェイト(140)
- 万年カレンダー・カレンダー類(17)
- ビジネスアイテム(89)
- 定規(112)
- 修正テープ・修正ペン(74)
- 消しゴム(111)
- のり・テープ・テープカッター(84)
- その他文具ノベルティ(456)
- マスク・マスクケース(120)
- 美容関連ノベルティ(126)
- コスメポーチ(120)
- あぶらとり紙(44)
- ミラー(117)
- 爪切り・ネイルケア(47)
- バスグッズ(128)
- 入浴剤(198)
- リラックス・癒しグッズ(127)
- ピルケース・サプリメントケース(18)
- 保険証ケース(11)
- 体脂肪計・歩数計(21)
- 健康・医療(457)
- アウトドア・レジャー(377)
- クーラーバッグ(85)
- ランチボックス(96)
- ボトル・ボトルケース(284)
- ボトル・ボトルケース(国内ブランド)(72)
- エコカイロ・カイロケース・湯たんぽ(71)
- トラベルグッズ(101)
- スポーツ(128)
- カーグッズ(46)
- ガーデニング(29)
- 傘・雨具(163)
- 催事用品(105)
- マグカップ(304)
- タンブラー・マグボトル(414)
- タンブラー・マグボトル(国内ブランド)(163)
- 箸・箸袋・箸置き(507)
- カトラリー(179)
- テーブルウェア・食器(367)
- グラスタンブラー・グラスマグ(44)
- コースター・ストロー(47)
- キッチン(1136)
- キッチンタイマー(19)
- 食品・調味料(576)
- 飲料(169)
- お菓子(308)
- お菓子【名入れ専用】(44)
- タオル・手ぬぐい(514)
- 名入れタオル・名入れハンカチ(194)
- ハンディファン・携帯扇風機(46)
- 消耗品(595)
- ティッシュ・ウェットティッシュ(337)
- クリーングッズ(509)
- ソーイングセット(13)
- シューズ関連(110)
- メジャー(18)
- 工具・DIYツール(23)
- 防災アイテム(561)
- 防災セット(235)
- 防犯・セキュリティグッズ(65)
- 防犯ブザー・ホイッスル(45)
- その他生活関連ノベルティ(640)
- カタログギフト(119)
品番:123360 リサイクルエコカイロ
品番:123360 リサイクルエコカイロ
特価:¥135(税込:¥148)
消費税の計算について
本商品は値下げ対象外商品です
名入れ最低ロット:120個
ご注文最低ロット:120個
在庫は流動的です。欠品の際はご容赦ください。
在庫状況・再入荷予定など詳細はお問合せください。
「名入れについてのご案内」
印刷形式・刷色・書体・よくある質問などをご覧いただけます。
レッド
ブルー
クリア
商品パッケージ
金属プレートが内蔵されています
金属プレートを数回押し曲げると液体が結晶化し発熱します
約40度の温かさが30分程度持続します
名入れ位置
画像をクリックすると上の画像が変わります。
-
■特価: ¥135 (税込:¥148)
消費税の計算について
本商品は値下げ対象外商品です - ■名入れ最低ロット: 120 個
- ■ご注文最低ロット: 120 個
在庫は流動的です。欠品の際はご容赦ください。
在庫状況・再入荷予定など詳細はお問合せください。
「名入れについてのご案内」
印刷形式・刷色・書体・よくある質問などをご覧いただけます。
- ■商品サイズ: 約直径95×12 mm
- ■本体色:
レッド、ブルー、クリア
- ■重量: 約98 g
- ■納品形態: 台紙入透明袋
- ■材質: PVC、酢酸ナトリウム、蒸留水
商品概要
| 商品サイズ: | 約直径95×12 mm |
|---|---|
| 本体色: |
レッド、ブルー、クリア
|
| 重量: | 約98 g |
| 包装形態: | 台紙入透明袋 |
| 材質: | PVC、酢酸ナトリウム、蒸留水 |
- ■最低ロット: 120 個
- ■名入れ標準納期:
約14
日

- ■印刷形式: パッド印刷
- ■場所: 表面中央
- ■可能サイズ: 縦25×横25mm
- ■可能色数: 1色
名入れ詳細
商品代とは別に名入れ代(版代・印刷代)が必要です。※例外あり
| 最低ロット: | 120 個 |
|---|---|
| 名入れ標準納期: | 約14日![]() |
| 印刷形式: | パッド印刷 |
| 場所: | 表面中央 |
| 可能サイズ: | 縦25×横25 mm |
| 可能色数: | 1色 |
![]()
カイロの中の金属プレートを数回パチッと押し曲げると液体が結晶化し発熱します。
約40度の温かさが30分程度持続するため、寒い季節に携帯しておきたいアイテムです。
寒い季節のイベント来場粗品や、各種購入特典にいかがでしょう。
※外気温により保温時間は差があります。
商品説明
カイロの中の金属プレートを数回パチッと押し曲げると液体が結晶化し発熱します。
約40度の温かさが30分程度持続するため、寒い季節に携帯しておきたいアイテムです。
寒い季節のイベント来場粗品や、各種購入特典にいかがでしょう。
※外気温により保温時間は差があります。

●ご注文・お支払い方法・ロット数について
- ※ご注文は、マイページにて見積書の内容をご確認いただき、見積書表示画面にある「注文を依頼する」ボタンを押してください。
- ※より詳しくはご利用ガイド内【ご注文の流れ】をご覧ください。
- ※お支払いは原則として前払いとなります。後払いをご希望の場合は別途ご相談ください。
- ※名入れありの場合の最低ご注文可能数はアイテムによって異なります。サンプルのご注文は1個からお受けします(例外あり)。
●名入れについての注意事項
- ※名入れノベルティグッズの作成には、商品代とは別に版代と印刷代が必要となります。
- ※納期は約2週間です(ご注文個数・加工内容・ご注文の時期によっても変わります)。
【名入れ用データについて】
- ※ロゴ・イラスト等を名入れされる場合はアウトライン化されたイラストレータのファイルをご用意ください。
- ※イラストレータのバージョンはCS6以下でご入稿ください。
- ※弊社にてデザインを作成する場合は別途データ作成費が必要となる場合があります。
- ※複雑なロゴやキャラクターなどは印刷できない場合があります。
- ※より詳しくは名入れについての解説ページをご覧ください。
おすすめの特集ページ